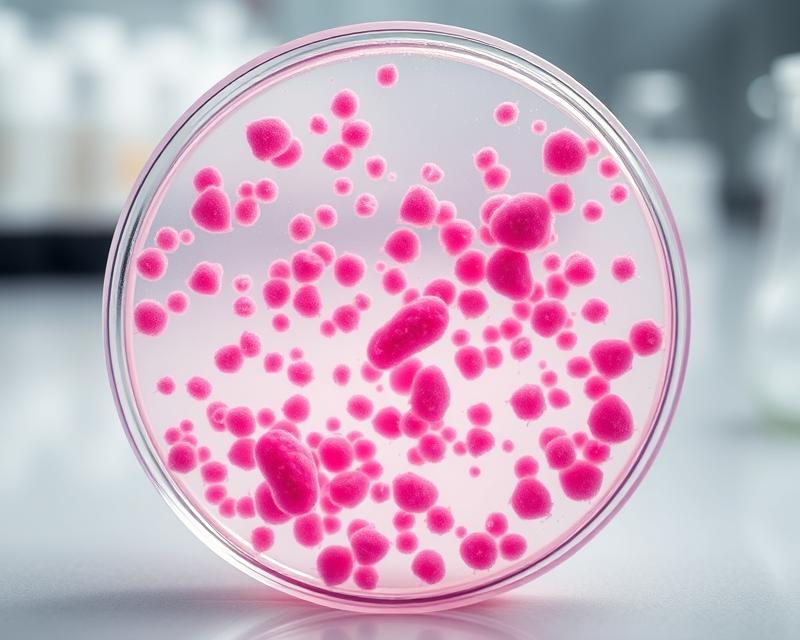
Gronkowiec – rodzaje, objawy i skuteczne metody leczenia

Gronkowiec, znany również jako Staphylococcus, to grupa bakterii, która odgrywa istotną rolę w zdrowiu człowieka. Wyróżniamy dwa główne typy: gronkowce koagulazododatnie, w tym najbardziej znany gronkowiec złocisty, oraz koagulazoujemne. Choć część z nich jest naturalnie obecna w organizmie, niektóre gatunki mogą wywoływać poważne infekcje, zwłaszcza u osób z osłabionym układem odpornościowym. Zrozumienie, czym jest gronkowiec i jakie ryzyko niesie ze sobą, jest kluczowe w zapobieganiu zakażeniom, które mogą prowadzić do groźnych komplikacji zdrowotnych. Jakie objawy mogą sygnalizować obecność tych bakterii w organizmie i jak skutecznie im przeciwdziałać?
Czym jest gronkowiec i jakie są jego rodzaje?
Gronkowce to grupa Gram-dodatnich bakterii należących do rodziny Staphylococcaceae. Te mikroorganizmy są integralną częścią naturalnej flory bakteryjnej człowieka, a ich naturalne siedliska obejmują skórę oraz błony śluzowe. Istnieją dwa główne rodzaje gronkowców:
- koagulazododatnie,
- koagulazoujemne.
Gronkowce koagulazododatnie, w tym znany gronkowiec złocisty (Staphylococcus aureus), mogą wywoływać poważne infekcje. Ten szczególny rodzaj bakterii jest głównym sprawcą zakażeń u ludzi, prowadząc do różnych dolegliwości, takich jak:
- infekcje skóry,
- infekcje tkanek miękkich,
- poważniejsze problemy ogólnoustrojowe.
Gronkowce koagulazoujemne, takie jak gronkowiec epidermidis (Staphylococcus epidermidis), zazwyczaj są nieszkodliwe, ale przy osłabionym układzie odpornościowym mogą stać się niebezpieczne.
Ze względu na swoją zdolność do zarażania, gronkowce są istotnym tematem w naukach medycznych oraz badaniach epidemiologicznych. Praktykowanie dobrych zasad higieny, takich jak:
- regularne mycie rąk,
- dezynfekowanie ran,
- utrzymywanie czystości w miejscach publicznych,
- unika kontaktu z osobami zakażonymi,
- stosowanie środków dezynfekujących.
może znacząco zmniejszyć prawdopodobieństwo zakażeń wywołanych tymi bakteriami. Warto również pamiętać, że w przypadku dostrzeżenia objawów infekcji, kluczowe jest szybkie działanie oraz konsultacja z lekarzem w celu skutecznego leczenia.
Jakie bakterie zaliczamy do rodzaju Staphylococcus?
Rodzaj Staphylococcus to zbiór bakterii, które mają istotne znaczenie w medycynie. W tej grupie wyróżniamy:
- gronkowca złocistego (Staphylococcus aureus),
- gronkowce koagulazoujemne.
Chociaż gronkowce koagulazoujemne są mniej zakaźne, mogą prowadzić do infekcji szpitalnych, zwłaszcza u pacjentów z osłabionym układem odpornościowym.
Gronkowiec złocisty jest znany ze zdolności do wywoływania różnych infekcji, które mogą dotyczyć:
- układu oddechowego,
- skóry,
- poważniejszych stanów, takich jak sepsa czy zapalenie wsierdzia.
Z kolei gronkowce koagulazoujemne, w tym Staphylococcus epidermidis, mogą stanowić problem w kontekście zakażeń związanych z:
- cewnikami,
- implantami medycznymi.
Ich obecność w takich przypadkach może prowadzić do poważnych komplikacji, co podkreśla wagę starannego monitorowania stanu pacjentów z wszczepionymi urządzeniami.
Zrozumienie różnorodności gatunków bakterii Staphylococcus jest kluczowe dla skutecznej diagnostyki oraz leczenia infekcji. Dzięki temu można również skuteczniej zapobiegać ich występowaniu w placówkach medycznych. Precyzyjne zidentyfikowanie typu bakterii ma znaczący wpływ na dobór odpowiedniej terapii, co jest niezwykle istotne dla polepszenia zdrowia pacjentów.
Kto jest najbardziej narażony na zakażenie gronkowcem?
Największe ryzyko zakażenia gronkowcem dotyczy osób z obniżoną odpornością, w tym:
- pacjentów przebywających w szpitalach,
- dzieci poniżej piątego roku życia,
- osób starszych,
- osób stosujących leki immunosupresyjne,
- osób prowadzących intensywny tryb życia.
U tych grup, układ odpornościowy często funkcjonuje gorzej, co sprawia, że są bardziej podatni na różne infekcje.
W szczególności pacjenci hospitalizowani są na to narażeni, zwłaszcza ci z:
- wszckepionymi protezami,
- wkłuciami centralnymi,
- leczeniem dożylnym.
U tych osób infekcje skórne wywołane przez gronkowce zdarzają się bardzo często. Małe dzieci, w fazie intensywnego rozwoju, mają niedojrzały system odpornościowy, co czyni je szczególnie wrażliwymi na różnorodne infekcje.
Nie możemy również zapominać o osobach starszych oraz tych, którzy stosują leki immunosupresyjne, na przykład pacjentach z nowotworami czy zakażonych wirusem HIV.
Dodatkowo, osoby prowadzące intensywny tryb życia, niezdrowo się odżywiające, lub narażone na długotrwały stres, mogą dostrzegać osłabienie swojego układu odpornościowego. To zjawisko zwiększa ich podatność na zakażenia gronkowcem. Dlatego warto zwracać uwagę na te aspekty, aby skuteczniej chronić siebie i bliskich przed potencjalnymi zagrożeniami.
Jakie są główne objawy zakażenia gronkowcem?
Objawy zakażenia gronkowcem różnią się w zależności od miejsca infekcji i szczepu bakterii. Zazwyczaj można zaobserwować:
- wysoką gorączkę,
- uczucie ogólnego zmęczenia,
- symptomy skórne, takie jak ból, czyraki, ropnie i liszajce.
Kiedy zakażenia rozprzestrzeniają się w organizmie, mogą prowadzić do poważnych komplikacji, takich jak:
- zapalenie płuc,
- bakteriemia,
- zapalenie tkanek miękkich.
Infekcje skórne wywołane przez gronkowca objawiają się:
- czerwonymi plamami,
- otwartymi ranami,
- ropnymi wydzielinami.
Te objawy mogą być bolesne i wpływać negatywnie na codzienną aktywność pacjentów. Gorączka oraz ogólne osłabienie to częste zjawiska towarzyszące infekcjom, co może sugerować rozwój stanu zapalnego w organizmie. Dlatego, gdy zauważysz takie objawy, nie zwlekaj z konsultacją z lekarzem; wczesna interwencja jest kluczowa, aby uniknąć poważniejszych skutków.
Różnorodność szczepów gronkowca, takich jak gronkowiec złocisty, może prowadzić do wielu niepożądanych objawów, w tym:
- zapalenie płuc,
- inne groźne stany, które wymagają pomocy medycznej.
Z tego powodu, wykonanie badań bakteriologicznych jest niezbędne dla prawidłowej diagnostyki i skutecznego leczenia infekcji gronkowcowych. Osobiście doświadczyłem, że szybko postawiona diagnoza oraz adekwatne leczenie mogą znacząco poprawić prognozy zdrowotne pacjenta.
Jakie są objawy zakażenia miejscowego i ogólnoustrojowego gronkowcem?
Zakażenie gronkowcem w obrębie skóry często manifestuje się poprzez:
- ropnie,
- czyraki,
- zapalenie mieszków włosowych.
Ropnie to zamknięte skupiska ropy, które mogą pojawiać się na skórze, zwłaszcza w miejscach narażonych na urazy czy nadmierne pocenie się. Z kolei czyraki to bolesne guzki, również wypełnione ropą, które rozwijają się w okolicy mieszków włosowych.
Zakażenia ogólnoustrojowe niosą ze sobą poważniejsze konsekwencje zdrowotne. Jednym z najgroźniejszych stanów jest sepsa, która zagraża życiu; organizm reaguje na infekcję ogólnym stanem zapalnym, co może prowadzić do niewydolności wielu narządów. Obserwuj następujące objawy:
- wysoka gorączka,
- osłabienie,
- bóle mięśni,
- kaszel,
- duszność,
- ból w klatce piersiowej,
- sztywność karku,
- nadwrażliwość na światło,
- intensywny ból głowy.
Jeżeli zauważysz te dolegliwości, nie zwlekaj i zgłoś się do lekarza. Szybka konsultacja pomoże w podjęciu odpowiednich działań diagnostycznych i terapeutycznych. Pamiętaj, że wczesna reakcja może znacznie zwiększyć efektywność leczenia.
Jakie zakażenia skóry, tkanek miękkich i układu oddechowego powoduje gronkowiec?
Gronkowiec złocisty, znany również jako Staphylococcus aureus, to bakteria odpowiedzialna za szereg zakażeń. Może wywoływać infekcje w obrębie:
- skóry,
- tkanek miękkich,
- dróg oddechowych.
Na skórze mogą pojawiać się problemy takie jak liszajec, czyraki oraz ropnie. Te dolegliwości nie tylko są nieprzyjemne, ale w przypadku braku odpowiedniej terapii mogą prowadzić do poważniejszych powikłań.
Oprócz tego gronkowiec bywa sprawcą zakażeń w tkankach miękkich, takich jak cellulitis czy abscesy. W kontekście układu oddechowego bakteria ta może być winowajcą zapalenia płuc oraz zapalenia zatok. Takie stany chorobowe stanowią szczególne zagrożenie dla osób z osłabionym układem immunologicznym.
Zakażenia Staphylococcus stanowią istotne ryzyko, zwłaszcza dla pacjentów cierpiących na przewlekłe schorzenia lub tych, którzy niedawno przeszli operacje, ponieważ ich organizmy mogą mieć ograniczoną zdolność do walki z infekcjami. Dlatego kluczowe jest wczesne rozpoznanie objawów związanych z gronkowcem oraz szybka konsultacja ze specjalistą. W moim doświadczeniu, szybka reakcja na pierwsze sygnały może mieć ogromne znaczenie w skuteczności leczenia i przebiegu choroby.
Jakie są objawy i leczenie gronkowcowego zapalenia szpiku oraz zatrucia pokarmowego?
Gronkowcowe zapalenie szpiku oraz gronkowcowe zatrucie pokarmowe to stany, które wymagają natychmiastowej diagnozy i odpowiedniego leczenia, ponieważ mogą prowadzić do poważnych komplikacji. Dlatego tak istotne jest poznanie ich objawów oraz dostępnych metod terapeutycznych.
Objawy gronkowcowego zapalenia szpiku obejmują:
- ból kości,
- gorączkę,
- ogólne złe samopoczucie.
Intensywny dyskomfort i osłabienie znacząco utrudniają codzienne życie. W diagnostyce kluczowe stają się badania obrazowe oraz mikrobiologiczne, które potwierdzają obecność gronkowca.
W leczeniu gronkowcowego zapalenia szpiku głównie stosuje się antybiotyki. Lekarze dobierają preparaty w zależności od:
- ciężkości zakażenia,
- ewentualnej oporności bakterii.
W cięższych przypadkach, gdy objawy są bardziej intensywne, leczenie może wymagać hospitalizacji. Efekty terapii różnią się w zależności od indywidualnej reakcji pacjenta.
Gronkowcowe zatrucie pokarmowe objawia się:
- nudnościami,
- wymiotami,
- biegunką.
Kluczowe w tym przypadku jest zapewnienie odpowiedniego nawodnienia oraz łagodzenie objawów. Należy uważnie obserwować stan pacjenta; w większości sytuacji wystarczające jest wsparcie objawowe, jednak w przypadku ciężkiego odwodnienia konieczna może być hospitalizacja.
W obu tych sytuacjach szybka interwencja jest kluczowa, aby zminimalizować ryzyko poważnych zdrowotnych konsekwencji. Właściwa pomoc medyczna pozwala na określenie odpowiedniej strategii leczenia, a wczesne rozpoznanie może znacząco poprawić prognozy dla pacjenta.
Jak rozpoznać i leczyć sepsę wywołaną przez gronkowca?
Sepsa wywołana przez gronkowca to poważny stan, który może stanowić zagrożenie dla życia i wymaga pilnej interwencji medycznej. Do typowych objawów zalicza się:
- wysoką gorączkę,
- przyspieszony oddech,
- ogólne osłabienie organizmu.
Takie objawy często wskazują na rozwijający się proces zapalny, co powinno budzić niepokój.
Diagnostyka sepsy polega na wykonywaniu badań mikrobiologicznych w celu potwierdzenia obecności gronkowca. Kiedy pojawia się podejrzenie sepsy, niezwykle ważne jest szybkie wdrożenie leczenia. Terapeutyczne działania obejmują:
- podawanie odpowiednich antybiotyków,
- zapewnienie wsparcia dla kluczowych funkcji życiowych pacjenta,
- czasami płynoterapia lub stosowanie leków stabilizujących ciśnienie krwi.
Takie interwencje są kluczowe, by poprawić stan chorego.
Skuteczna terapia sepsy wywołanej przez gronkowca jest niezmiernie istotna, ponieważ znacząco zwiększa szanse na pozytywny przebieg oraz minimalizuje ryzyko powikłań. Wczesne rozpoznanie i odpowiednie leczenie mogą w ogromnym stopniu przyczynić się do szybkiego powrotu do zdrowia. Dlatego, jeśli zauważysz jakiekolwiek objawy sepsy, nie czekaj i skonsultuj się z lekarzem, by jak najszybciej podjąć potrzebne kroki.
Jakie toksyny produkuje gronkowiec i jaki mają wpływ na organizm?
Gronkowiec złocisty produkuje toksyny, które mogą poważnie zaszkodzić zdrowiu człowieka. Najistotniejsze z nich to enterotoksyny oraz toksyna wstrząsu toksycznego. To właśnie enterotoksyny są główną przyczyną zatruć pokarmowych, mogących wystąpić po spożyciu żywności zanieczyszczonej tą bakterią. Objawy zatruć mogą być bardzo nieprzyjemne – często towarzyszą im:
- bóle brzucha,
- wymioty,
- gorączka.
Gdy tylko zauważysz te symptomy, nie zwlekaj z udaniem się do lekarza, aby uniknąć poważniejszych komplikacji zdrowotnych.
Toksyna wstrząsu toksycznego ma potencjał wywołania groźnego wstrząsu. Objawia się on:
- nagłym spadkiem ciśnienia krwi,
- trudnymi do kontrolowania reakcjami immunologicznymi.
Działanie tej toksyny może prowadzić do znacznego uszkodzenia tkanek oraz stanów zapalnych, co stanowi realne zagrożenie dla życia. W sytuacji podejrzenia wstrząsu toksycznego niezbędna jest natychmiastowa pomoc medyczna.
Produkcja tych toksyn sprawia, że gronkowiec złocisty jest odpowiedzialny za poważne choroby, które wymagają szybkiej diagnozy i właściwego leczenia. Kluczowe jest zrozumienie mechanizmu działania tych toksyn, co pomaga w profilaktyce oraz efektywnym leczeniu infekcji wywołanych przez ten patogen. Ponadto, istotne jest, aby nie zapominać o:
- dbaniu o higienę,
- starannym przygotowywaniu żywności.
Te działania mogą znacząco zredukować ryzyko zakażeń.
Jak gronkowiec tworzy biofilm i dlaczego to utrudnia leczenie?
Gronkowiec, rodzaj bakterii, potrafi tworzyć biofilm, co znacząco komplikuje leczenie zakażeń. Biofilm to zbiór komórek bakteryjnych otoczonych substancjami międzykomórkowymi, który przylega do różnych powierzchni, w tym do ciał obcych, takich jak protezy czy cewniki. Ta ochronna warstwa działa jak tarcza, zabezpieczając bakterie przed działaniem antybiotyków oraz układem odpornościowym.
Jednym z głównych wyzwań związanych z biofilmem jest ograniczona możliwość przenikania antybiotyków. Wiele leków ma trudności z dotarciem do bakterii znajdujących się w biofilmie, co sprawia, że tradycyjne metody leczenia stają się mniej efektywne. Co więcej, bakterie w biofilmie mogą być bardziej oporne na terapie, co zwiększa trudności w ich eliminacji.
Z tego powodu, zakażenia spowodowane gronkowcem, szczególnie te związane z implantami lub innymi obcymi ciałami, są znacznie bardziej skomplikowane do wyleczenia. W takich przypadkach często konieczne jest zastosowanie bardziej intensywnych metod, takich jak:
- chirurgiczne usunięcie wszczepów,
- skomplikowana terapia antybiotykowa.
Ważne jest, aby pamiętać, że wczesna interwencja może znacząco poprawić rokowania. Dlatego nie warto lekceważyć objawów zakażeń związanych z ciałami obcymi.
Jakie są możliwe powikłania zakażenia gronkowcem?
Zakażenie gronkowcem może prowadzić do poważnych komplikacji, które zagrażają zdrowiu, a nawet życiu pacjenta. Wśród najważniejszych z nich wymienia się:
- sepsa,
- zapalenie płuc,
- zapalenie wsierdzia,
- bakteriemia.
Sepsa to stan grożący życiem, który występuje, gdy bakterie dostają się do krwiobiegu. To może prowadzić do ogólnoustrojowej reakcji zapalnej, skutkującej uszkodzeniem narządów, a w skrajnych przypadkach – niewydolnością wielonarządową. W moim doświadczeniu, szybka interwencja medyczna ma kluczowe znaczenie w ograniczeniu ryzyka poważnych skutków.
Zapalenie płuc to niebezpieczna komplikacja, szczególnie u osób z osłabionym układem immunologicznym. Zakażenie gronkowcem w płucach powoduje trudności w oddychaniu i wymaga natychmiastowego leczenia. Objawy zapalenia płuc mogą przypominać inne schorzenia, dlatego nie należy ich lekceważyć.
Zapalenie wsierdzia to stan zapalny wewnętrznej wyściółki serca, prowadzący do poważnych problemów zdrowotnych, a w skrajnych przypadkach – do śmierci, jeśli nie zostanie szybko zdiagnozowany i leczony. W przypadku objawów, takich jak gorączka czy ból w klatce piersiowej, warto jak najszybciej skonsultować się z lekarzem.
Bakteriemia, czyli obecność bakterii we krwi, stanowi poważne zagrożenie. Może przyczynić się do rozprzestrzenienia się zakażenia w organizmie, co zagraża życiu pacjenta. Uważam, że regularne badania i monitorowanie stanu zdrowia są niezwykle ważne, szczególnie dla osób z grup ryzyka.
Warto pamiętać, że niewłaściwe leczenie zakażenia gronkowcem może prowadzić do poważnych konsekwencji. W przypadku jakichkolwiek objawów sugerujących zakażenie, niezbędne jest jak najszybsze skontaktowanie się z lekarzem.
Jak rozpoznać zakażenie gronkowcem – metody diagnostyczne i badania bakteriologiczne?
Rozpoznanie zakażenia gronkowcem wymaga wykorzystania różnych metod diagnostycznych. Kluczową rolę odgrywają badania mikrobiologiczne, w tym posiew, które pozwalają na identyfikację konkretnego szczepu bakterii oraz ustalenie skutecznej terapii.
Kiedy lekarz podejrzewa zakażenie gronkowcem, swoje przypuszczenia opiera na analizie objawów klinicznych, które mogą manifestować się zarówno na skórze, jak i w całym organizmie. Laboratoria analizują próbki:
- krwi,
- moczu,
- tkanki z zaatakowanego obszaru.
Aby potwierdzić obecność bakterii.
W przypadku zatruć pokarmowych warto, aby podejrzane produkty zostały przesłane do laboratorium, gdzie można wykryć:
- toksyny,
- szczepy bakterii je produkujące.
Dzięki temu diagnostyka staje się bardziej precyzyjna, co umożliwia wdrożenie odpowiedniego leczenia.
W diagnostyce zakażeń gronkowcowych istotne jest również monitorowanie oporności na leki, która może znacząco wpłynąć na dobór terapii. Regularne badania, takie jak posiew, są niezbędne dla skutecznego zarządzania infekcjami gronkowcowymi.
W przypadku wykrycia oporności na antybiotyki, lekarz rozważy alternatywne metody leczenia, co podkreśla znaczenie rzetelnej diagnostyki.
Jak leczenie gronkowca przebiega z użyciem antybiotyków?
Leczenie zakażeń wywołanych przez gronkowce opiera się przede wszystkim na stosowaniu antybiotyków. Kluczowym krokiem w wyborze odpowiednich preparatów jest analiza wyników antybiogramu, który ujawnia, jakie szczepy bakterii są wrażliwe na konkretne leki. Ta informacja ma istotne znaczenie, ponieważ decyduje o skuteczności całej terapii.
W przypadku takich zakażeń najczęściej stosuje się:
- klindamycynę,
- cefadroksyl,
- spiramycynę,
- mupirocynę,
- chloramfenikol.
Wybór leku uzależniony jest od stopnia zaawansowania infekcji oraz poziomu oporności danego szczepu. W sytuacjach ciężkich, operacja może być niezbędna, aby oczyścić ranę i usunąć zakaźne tkanki.
Forma leczenia różni się w zależności od miejsca oraz ciężkości zakażenia. Antybiotyki mogą być stosowane:
- miejscowo,
- dousto,
- dożylnie.
Gdy pacjent jest oporny na tradycyjne leki, lekarz może rozważyć zmianę terapii. W takich wypadkach można sięgnąć po alternatywne antybiotyki lub terapie wspomagające. Kluczowe jest śledzenie reakcji organizmu na nowo wprowadzone leczenie, by jak najlepiej dostosować je do potrzeb konkretnego pacjenta.
Jak radzić sobie z opornością gronkowca na leki?
Aby skutecznie stawić czoła problemowi oporności gronkowca na leki, niezbędne jest wprowadzenie właściwej terapii antybiotykowej oraz systematyczne monitorowanie wyników leczenia. Oporność, szczególnie w kontekście szczepu Staphylococcus aureus, staje się poważnym wyzwaniem klinicznym, które wymaga indywidualnego podejścia do każdego pacjenta.
Pierwszym krokiem w leczeniu jest zastosowanie antybiotyków, które wciąż wykazują skuteczność przeciwko opornym szczepom. Gdy wystąpi zakażenie wywołane przez gronkowca, lekarz może zalecić przeprowadzenie testów wrażliwości. Tego rodzaju badania pomogą określić, które leki będą efektywne w danym przypadku. W sytuacji, gdy standardowe antybiotyki nie przynoszą rezultatów, warto zasięgnąć porady dotyczącej alternatywnych metod leczenia. Na przykład:
- rozważenie terapii skojarzonej z wykorzystaniem różnych antybiotyków,
- innowacyjne leki, które wciąż przechodzą badania.
Nie można jednak zapominać o prewencji zakażeń gronkowcowych. Zachowanie odpowiednich praktyk higienicznych oraz stałe monitorowanie pacjentów z grup ryzyka są niezwykle istotne. W wielu przypadkach pomocne mogą okazać się także terapie wspomagające, takie jak:
- dostosowanie diety,
- wzmacnianie układu odpornościowego,
- redukcja ryzyka wystąpienia zakażeń.
Ważne jest, aby zrozumieć, że efektywna walka z opornością gronkowca na leki wymaga bliskiej współpracy między pacjentem a lekarzem. Lekarze często modyfikują strategię leczenia na podstawie zmieniających się właściwości bakterii oraz uzyskiwanych wyników, co pozwala na skuteczniejsze zarządzanie problemem.
Jak zapobiegać zakażeniom gronkowcowym?
Aby skutecznie zapobiegać zakażeniom gronkowcowym, kluczowe jest przestrzeganie zasad higieny osobistej oraz unikanie kontaktu z osobami zakażonymi. Szczególnie istotne jest dbanie o czystość rąk. Regularne mycie rąk mydłem i wodą przez przynajmniej 20 sekund pozwala usunąć wiele patogenów, w tym bakterie gronkowca. Staraj się myć ręce z większą uwagą, zwłaszcza po powrocie do domu lub przed jedzeniem.
W miejscach o podwyższonym ryzyku zakażeń, takich jak szpitale, zaleca się stosowanie standardowej izolacji kontaktowej, co znacznie ogranicza rozprzestrzenianie się bakterii. Ponadto, unikaj dzielenia się osobistymi przedmiotami, takimi jak:
- ręczniki,
- maszynki do golenia,
- inne akcesoria higieniczne.
Te przedmioty mogą być nośnikiem infekcji. Nawet drobne akcesoria niosą ze sobą ryzyko zakażeń, dlatego warto zachować ostrożność.
Prowadzenie zdrowego stylu życia, który obejmuje:
- regularną aktywność fizyczną,
- zrównoważoną dietę,
- odpowiednią ilość snu,
wspiera nasz układ odpornościowy i zmniejsza ryzyko infekcji. W przypadku ran ważne jest ich odpowiednie zakrywanie i pielęgnacja aż do całkowitego zagojenia. Regularne monitorowanie ich stanu oraz czyszczenie może być kluczowe w zapobieganiu powikłaniom.
Jaką rolę mają higiena osobista i higiena rąk w prewencji gronkowca?
Higiena osobista oraz staranna dbałość o czystość rąk odgrywają niezwykle istotną rolę w zapobieganiu zakażeniom gronkowcowym. Regularne mycie rąk wodą i mydłem skutecznie eliminuje bakterie, w tym Staphylococcus, które mogą prowadzić do różnych infekcji. W środowisku szpitalnym, gdzie ryzyko zakażeń wzrasta, szczególna uwaga na czystość rąk i ciała jest kluczowa w ograniczaniu rozprzestrzeniania się tych niebezpiecznych patogenów.
Pamiętaj, że mycie rąk powinno być rutyną nie tylko przed jedzeniem czy po wyjściu z toalety. Ważne jest, aby to robić także po kontakcie z potencjalnie zanieczyszczonymi powierzchniami. Dodatkowo, unikaj dzielenia się osobistymi akcesoriami:
- ręczniki,
- maszynki do golenia,
- sztućce,
- szczoteczki do zębów.
to także ma znaczenie dla zachowania zdrowia. W przypadku ran, ich odpowiednie zabezpieczenie znacząco zmniejsza ryzyko, że bakterie dostaną się do organizmu.
Przestrzegając tych zasad, zmniejszamy ryzyko zakażeń gronkowcem, chroniąc tym samym siebie i innych dookoła.
Jak wzmacniać układ odpornościowy, aby zmniejszyć ryzyko zakażenia?
Wzmacnianie układu odpornościowego stanowi kluczowy element w redukcji ryzyka infekcji, w tym tych spowodowanych przez gronkowce. Aby to osiągnąć, warto skupić się na kilku istotnych aspektach.
Zdrowa dieta ma ogromny wpływ na zachowanie silnego układu immunologicznego. Powinna obfitować w:
- owoce,
- warzywa,
- białko,
- zdrowe tłuszcze.
Te składniki dostarczają niezbędnych witamin oraz minerałów. Spożywanie pokarmów bogatych w antyoksydanty – takich jak jagody, cytrusy czy orzechy – wspiera funkcje obronne organizmu. Z własnego doświadczenia mogę powiedzieć, że dodanie większej ilości warzyw do mojej diety skutkuje lepszym samopoczuciem.
Regularna aktywność fizyczna odgrywa równie ważną rolę w podtrzymywaniu odporności. Eksperci sugerują, aby poświęcić co najmniej 150 minut na umiarkowane ćwiczenia w ciągu tygodnia. Ruch poprawia krążenie, co z kolei ułatwia transport komórek odpornościowych do miejsc zapalnych – to kluczowe w walce z infekcjami.
Dodatkowo warto rozważyć zażywanie suplementów diety, zwłaszcza w okresach zwiększonego ryzyka chorób, takich jak sezon grypowy. Preparaty zawierające:
- witaminę C,
- witaminę D,
- cynk
mogą pomóc organizmowi w prawidłowym funkcjonowaniu układu immunologicznego. Na własnej skórze przekonałem się, że regularne przyjmowanie tych suplementów zimą przynosi zauważalne korzyści.
W trosce o zdrowie całego organizmu ważne jest, aby stosować odpowiednią dietę, regularnie się ruszać oraz, jeśli to konieczne, wprowadzać suplementy. Dobre nawyki żywieniowe, aktywność fizyczna i wsparcie w postaci dodatkowych mikroskładników mogą znacząco poprawić naszą odporność.

Najnowsze komentarze